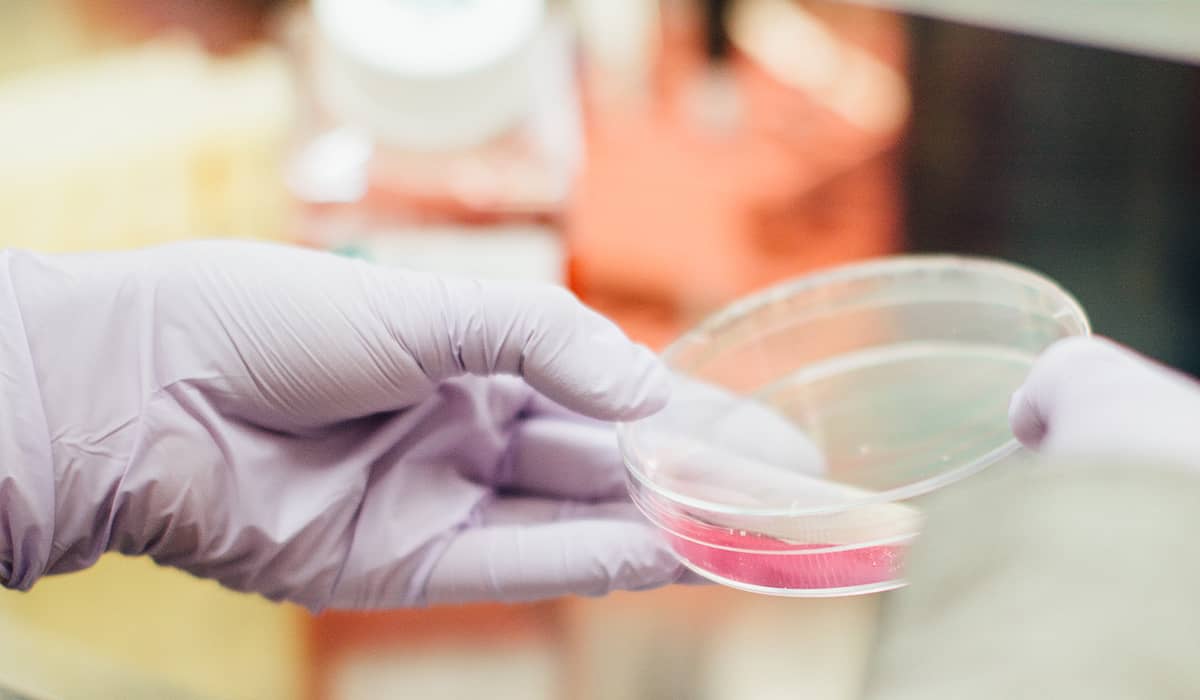
Prostat Kanserinde PSMA PET Nedir?

İçindekiler
- Prostat Biyopsisi Çeşitleri
- Eski Tip: Klasik Prostat Biyopsisi
- Yeni Tip: Prostat Füzyon Biyopsisi
- Prostat Biyopsisi Hangi Durumlarda Yapılmalıdır?
- Prostat Füzyon Biyopsisi Uygulaması
- Biyopsiye Hazırlık
- Biyopsi Uygulaması
- Biyopsi Sonrası
- Uygulama Tekrarlanabilir Mi?
- PI-RADS Sınıflaması
Prostat biyopsisi, prostat bezinden küçük prostat parçaları alma işlemidir. Biyopsi ile alınan parçalar özel boyalarla boyanarak mikroskop altında incelenir. Bu parçaları inceleyen patolog hastada prostat kanseri var olup olmadığını; eğer prostat kanseri varsa kanserin ne kadar saldırgan olduğu da prostat biyopsisi sayesinde belirlenir.
Kesin prostat kanseri tanısı prostat biyopsisi sayesinde konur.
Prostat Biyopsisi Çeşitleri
Prostat biyopsisi 2 farklı tipte yapılmaktadır.
Eski Tip: Klasik Prostat Biyopsisi
Klasik tip prostat biyopsisi hemen hemen her hastanenin üroloji servisinde uygulanabilir.
Klasik tipteki biyopside yalnızca transrektal ultrasonografi kullanılır. Yani biyopsi öncesinde MR inceleme işlemi yoktur.
Hastanın rektumundan uzatılan ultrason probu ile prostattan rastgele olacak şekilde 12 parça alınır. Bu işlem esnasında üroloji uzmanı prostattaki kanserli alanları (varsa) görmeden işlem yapar.
Yeni Tip: Prostat Füzyon Biyopsisi
Şu anda ülkemizde sayılı hastanelerde uygulanan prostat füzyon biyopsisi ile saldırgan prostat kanserinin tam olarak tespit yapılabilmektedir.
İşlem öncesinde hastaya multiparametrik prostat MR'ı çekilir. Kanser şüphesi görünün alanlar MR üzerinde işaretlenir. Sonrasında anestezi ile uyutulan hastanın makatından ultrason probu ile girilir. Biyopsi makinesi yardımı ile MR görüntüleri ve ultrason görüntüleri eşleştirilir. Her hangi birinin göremediği kanserli bölgeler bu yöntemle net olarak belirlenir.
Prostattan örnek alma işlemi rastgele olarak yapılmaz. Kanser riski taşıyan bölgelerden örnek alınır ve kanserin yüksek oranda saptanması sağlanır.

| Klasik Prostat Biyopsisi | Prostat Füzyon Biyopsisi |
| Hastaya prostat biyopsi öncesi MR çekilmez. | Hastaya prostat biyopsisi öncesinde multiparametrik prostat MR çekilir. |
| Genellikle hasta uyutulmaz ve hastaya lokal anestezi yapılır. | Genellikle hasta uyutularak anestezi altında işlem yapılır. |
| Hasta genellikle ağrı hisseder. | Hasta ağrı duymaz. |
| Özellikle hızlı yayılan agresif prostat kanserleri gözden kaçabilir. | Özellikle hızlı yayılan agresif prostat kanserleri gözden kaçırılmaz. |
| Tedavi planlaması yanlış yapılabilir. | Tedavi planlaması doğru yapılır. |
Prostat Biyopsisi Hangi Durumlarda Yapılmalıdır?
Prostat kanserinin kesin tanısını koymak için kanser riski olan kişilere prostat biyopsisi yapmak en mantıklı yaklaşımdır.
Prostat kanseri açısından risk altında olan kişileri şu şekilde sıralayabiliriz:
- Kanda PSA düzeyi yüksek olan erkekler
- Parmakla rektum muayenesinde asimetrik bir prostatı olanlar veya prostat yüzeyinde sertlik, kitle bulunan erkekler
- Yapılan MR görüntülemelerinde prostat içinde kanser açısından şüpheli alan saptanan erkekler
Yalnızca MR'da görüntülenen riskli bölgelerden prostat biyopsisi yapıldığında kanserli bölgelerin %10 kadarı tespit edilemez. Bu sebeple multiparametrik MR görüntülemesinin de kullanılması önerilmektedir.

Prostat Füzyon Biyopsisi Uygulaması
Biyopsiye Hazırlık
Prostat füzyon biyopsisi öncesinde hastanın MR'ı çekilir.
İşlem sırasında hasta anestezi ile uyutulmuş olur. Anesteziden 6-8 saat öncesinden yeme-içme işleminin kesilmesi gerekir.
Biyopsi öncesinde hastada tedavi edilmemiş idrar yolu enfeksiyonu olmadığından emin olmak için bazı testler yapılır.
Biyopsi işlemi makattan yapıldığı için öncesinde lavman işlemi ile bağırsaklar temizlenir.
Biyopsi öncesinde hastaya antibiyotik verilmesi de önerilen işlemler arasındadır.
Prostat füzyon biyopsisi yaptırmadan 1 hafta kadar önce kan sulandırıcı ilaçların kullanımının sınırlandırılması gerekir. Bu sebeple üroloji uzmanınıza kullandığınız ilaçları mutlaka belirtmelisiniz.
Biyopsi Uygulaması
Prostat biyopsisi işleminde hastanın makatına ultrason probu yerleştirilir. Prostatın önü, arkası ve konumu belirlenir.
İncelemek üzere alınacak prostat parçaları kalın bağırsağı delinmesi yöntemi ile alınabilir. Bu yola transrektal prostat biyopsisi adı verilir.
Transrektal Prostat Biyopsi: Yan olarak yatırılmış hastanın makatından kalın bağırsağına transrektal ultrason yerleştirilir. Transrektal ultrason ile uzatılan iğne hızlı bir şekilde prostat ulaşır ve incelenecek örnek parçaları alma işlemi yapılır. Prostatın değişik noktalarından 10-12 parça alınır. İşlem ortalama 25 dakika sürer.
Transperineal Prostat Biyopsi: Transperineal biyopsi çok sık kullanılan bir yöntem değildir. Hasta sırt üstü yada yan olarak yatırılır. İşlem öncesinde hastanın cildi sterilize edilir.
Prostatı tutmak için hastanın rektumundan parmak ile girilir. Perine bölgesinden iğne sokulur ve prostata batırılır. İncelenmek için alınacak parçalar iğne döndürülerek alınır. İşlem ortalama 30 dakika sürer.
Biyopsi Sonrası
Prostat biyopsisinden sonra hastanın ortalama 6-8 saat dinlenmesi gerekir.
Hastanın pelvik bölgesinde ağrı olabilir.
İşlemi takip eden 4-5 gün boyunca idrarda kan görülebilir. Aynı şekilde takip eden 6 hafta boyunca menide de kan görülebilir.
Transrektal biyopsi işlemi sonrasında hastanın makatından kanama olabilir.
Prostat füzyon biyopsisi öncesinde antibiyotik alma işlemi yapılmadığında akut prostatit (prostat enfeksiyonu) oluşma riski bulunur.
Uygulama Tekrarlanabilir Mi?
İlk prostat biyopsi sonucunda "iyi huylu prostat büyümesi veya prostat iltihabı" gelmesine rağmen; hastanın takiplerinde PSA değerlerinde artış olması yada parmakla rektum muayenesinde anormal bulgu olması durumunda biyopsinin tekrarı gerekebilir.
İlk prostat biyopsi sonucu “atipik küçük asiner proliferasyon (ASAP)” gelmesi durumunda biyopsi tekrar edilebilir.
İlk prostat biyopsi sonucu en az 3 örnekte “yüksek dereceli PIN” saptandığı durumda da biyopsi tekrarlanabilir.
PI-RADS Sınıflaması
Avrupa Urogenital Radyoloji Derneği 2012 yılında “Prostat İncelemesinin Raporlanması ve Veritabanı Sistemi” (PI-RADS) adlı sınıflandırmayı yayınladılar. Bu sınıflama 2014 yılında güncellendi ve güncellenmeye devam ediyor.
Bu sınıflama radyologların prostat içindeki lezyonları belli kriterlere göre değerlendirmesini amaçlamaktadır. Böylece değerlendirmelere bir standardizasyon getirmeye çalışılmaktadır.
Çekilmiş olan multiparametrik MR görüntüleri bu konudaki deneyimli radyologlar tarafından incelenir. Prostat içindeki lezyonlar 1 ile 5 arasında puanlanır.

PI-RADS 1-2 için lezyonlara klasik olarak prostat biyopsisi yapılması önerilir.
PI-RADS 3 için hastanın diğer bulguları da incelenir ve ona göre prostat biyopsisine karar verilir.
PI-RADS 4-5 için lezyonların prostat kanseri bakımından riskli yüksek riskli olduğu yorumu yapılır.
MR füzyon biyopsisinde 3 farklı yöntem bulunuyor.
MR Altında Biyopsi: MR görüntülemede belirlenen noktadan yüksek doğrulukla biyopsi alınabilir.
Bu yöntemde yalnızca MR'da görüntülenen noktalardan biyopsi yapılmaz. Sistematik biyopsi de yapılmalıdır. Bu işlem de uzun zaman alması ve pahalı olması nedeni ile çok tercih edilmez.
Kognitif MR Biyopsi: MR'da işaretlenen noktalardan biyopsi örnekleri alınır.
Bu yöntemde, ufak boyuttaki şüpheli noktalar gözden kaçabilir.
Yazılım Yardımlı MR Ultrason Füzyon Biyopsi: Prostat ultrason ile incelenir. MR'dan alınan görüntüler bir bilgisayar yazılımı ile birleştirilir. Sonuçta 3 boyutlu bir MR görüntüsü oluşturulur.
Bu yöntemde, şüpheli tüm lezyonlardan örnek alma işlemi gerçekleştirilir.

Yorumlar
10Yorum Yazın
Henüz yorum yapılmamış. İlk yorumu siz yapın!